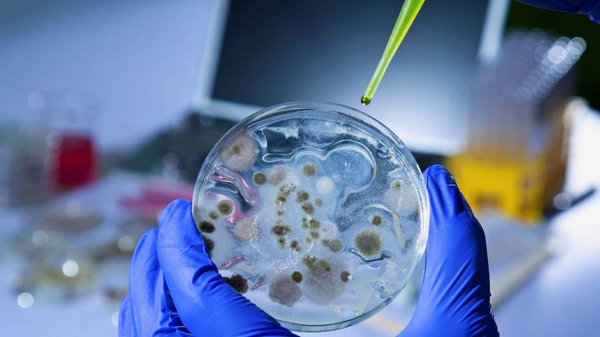
抗菌塑料制品的存在具有必要性

塑料制品
深圳市 新 能 塑 胶 制品 有 限 公 司
SHENG ZHENG XING NENG PLASTIC CO LTD
网址:www.xnsujiao.com.cn
website:www.xnsujiao.com.cn
电话:0086+0755-136 2096 0796.
The phone:0086+0755-13620960796.
SHENG ZHENG XING NENG PLASTIC CO LTD
网址:www.xnsujiao.com.cn
website:www.xnsujiao.com.cn
电话:0086+0755-136 2096 0796.
The phone:0086+0755-13620960796.
- 作者: 吴R
- 来源:
- 日期: 2022-05-01
- 浏览次数: 5123次
21世纪抗菌塑料的发展趋向是将智能化与经济发展、文化发展紧密联系,更进一步融进现代生活。伴随着我国人民生活水平及环境保护意识的提升,抗菌塑料产品的要求也将形成潜在性的较大销售市场,抗菌塑料产品的制造将变成主要的新型产业行业。抗菌塑料产品对造就清洁、身心健康自然环境有着主要作用,并且会形成较好的社会经济效益和社会效益。
21世纪抗菌塑料的发展趋向是将智能化与经济发展、文化发展紧密联系,更进一步融进现代生活。伴随着我国人民生活水平及环境保护意识的提升,抗菌塑料产品的要求也将形成潜在性的较大销售市场,抗菌塑料产品的制造将变成主要的新型产业行业。抗菌塑料产品对造就清洁、身心健康自然环境有着主要作用,并且会形成较好的社会经济效益和社会效益。抗菌塑料的产品研发与使用为维护我们身心健康筑起了一道健康天然屏障,针对改进我们生存条件,降低病症,维护健康中国,有着非常主要的实际意义。应扩大对复合型抗菌剂的科学研究,产品研发新式抗菌剂,用以生产加工性能更佳的抗菌材料,以满足世界各国日益突出的抗菌塑料市场的需求。
抗菌塑料产品的使用,可降低或避免人和人之间、人和物、物与物相互间的病毒交叉式感染,可将保健医疗的方式,从业后的医治变化为前提的防止,为大家建立一个安全健康的生活环境,大大减少细菌性感染的概率。
上一篇: 多功能料理机/炒菜机 下一个潜在爆款赛道
下一篇: 抗菌、灭菌、杀菌、抑菌一字之差的意思
主營:选购塑料托盤價格深圳塑料托盤塑料卡板深圳塑料卡板塑料周轉箱深圳塑料周轉箱塑料筐深圳塑料筐塑料零件盒深圳零件盒二手塑料托盤天津塑料托盤上海塑料托盤北京塑料托盤塑料托盤求購塑料托盤中山塑料卡板江門塑膠卡板中山周轉箱江門塑料筐對開印刷托板四開印刷托盤廣東印刷卡板定购东莞塑胶卡板,惠州塑胶卡板厂家 买塑料托盘©深圳市新能塑膠製品有限公司ICP備案號: 粵ICP備19020968號
 粵公網安備44030902000470號
粵公網安備44030902000470號
電話:0086-0755- 136 2096 0796 .
地址:中國.廣東省深圳市龍華新區大浪街道華寧路4號
網址: www.xnsujiao.com.cn
郵箱:xnsujiao#foxmail.com(#換成@)
本站部分图文来源网络,如有侵权问题请通知我们处理!
做网站维护





